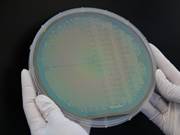

Lab4MEMS aims to establish a European Pilot Line for innovative technologies on advanced piezoelectric and magnetic materials, including advanced packaging technologies to meet the ever evolving...
Lab4MEMS aims to establish a European Pilot Line for innovative technologies on advanced piezoelectric and magnetic materials, including advanced packaging technologies to meet the ever evolving...
SINTEF has developed a new tool for mapping of noise from road traffic. It is in use by NPRA – Norwegian Public Road Administration to monitor the noise pollution that bothers 1 500 000 Norwegians...
The driving goal of ARMS is to create the future of Norwegian goods manufacturing industry. This is achieved through professionalizing the ability to mass produce individually customized goods to...
The PlusUltra project aims at providing new concepts for photoelectrocatalaytic conversion of H2O, CO2, and N2 to fuels, useful chemicals, and fertilizers using renewable energy. The biosphere...
Unfavorable exposures for workers in the fishing fleet, such as a cold, noise, heavy lifting, inconvenient working hours, long work days and excessive strain are factors that may negatively...
The project started in September 2008 and was completed by end of November 2011. ECCO was a research project that aimed to accelerating the development of CO2 Capture and Storage (CCS), which is...
KRAV is a research project within combined heat and power production from biomass. Goal To increase the knowledge within small-scale biomass CHP systems to be able to support Norwegian industry...
Compliance by Design of Data/AI Operations and Pipelines Objective Artificial intelligence (AI) and data services have experienced rapid and remarkable advancements in recent years, driving...
More efficient rail mobility via innovative AI-based methods, by enabling optimized planning of rail replacement services and cost-effective infrastructure investment decisions. Managing...
The production of photovoltaic modules generates significant resource flows, much of which currently becomes waste, including silicon kerf, graphite, and silica from ingot production. The ICARUS...
BioBIVE has a goal to develop bio-based and bioactive delivery systems to control fungal plant pathogens of different horticultural crops decreasing fossil-based materials and pesticide use,...
The project is a nine-year research-based evaluation of the Escalation Plan for Mental Health. The evaluation will provide knowledge about implementation and results and form the basis for...
This project is working on new insulation liquids for transformers that can be safer, more sustainable, and better at cooling. Background: Investments in the power system Considerable investments...
INESCTEC.OCEAN is a Portuguese Centre of Excellence addressing marine structures, marine robotics, ocean energy and ocean data, with SINTEF OCEAN as strategic partner. Led by Portuguese INESC...
The FUSE vision is to rapidly reduce emissions from the global fleet by unlocking the full potential of operational data through fusing AI and ship hydrodynamics for next generation voyage...
To create innovations securing sustainability and competitiveness of the maritime transport sector. By developing new knowledge, methods and technologies and educating students. SFI Smart...
AquaStar will develop an autonomous underwater system for targeted inspection and repair of holes in fish farm nets. The aim is to improve today's inspection routines and enable the immediate...
Envelope mAterial System with low Impact for Zero Energy Renovation and construction EASI ZERo focuses on a unique package of easy to install envelope components towards building’s renovation for...
The main objective of the IMAGINE project is to develop a hydrogen gas fueled combustion engine tailored to withstand hydrogen degradation, ensuring material integrity and durability of critical...
Refinery integration, scale-up and certification for aviation and marine biofuels production. The REFOLUTION project aims to demonstrate the cost-effective production of advanced biofuels for...